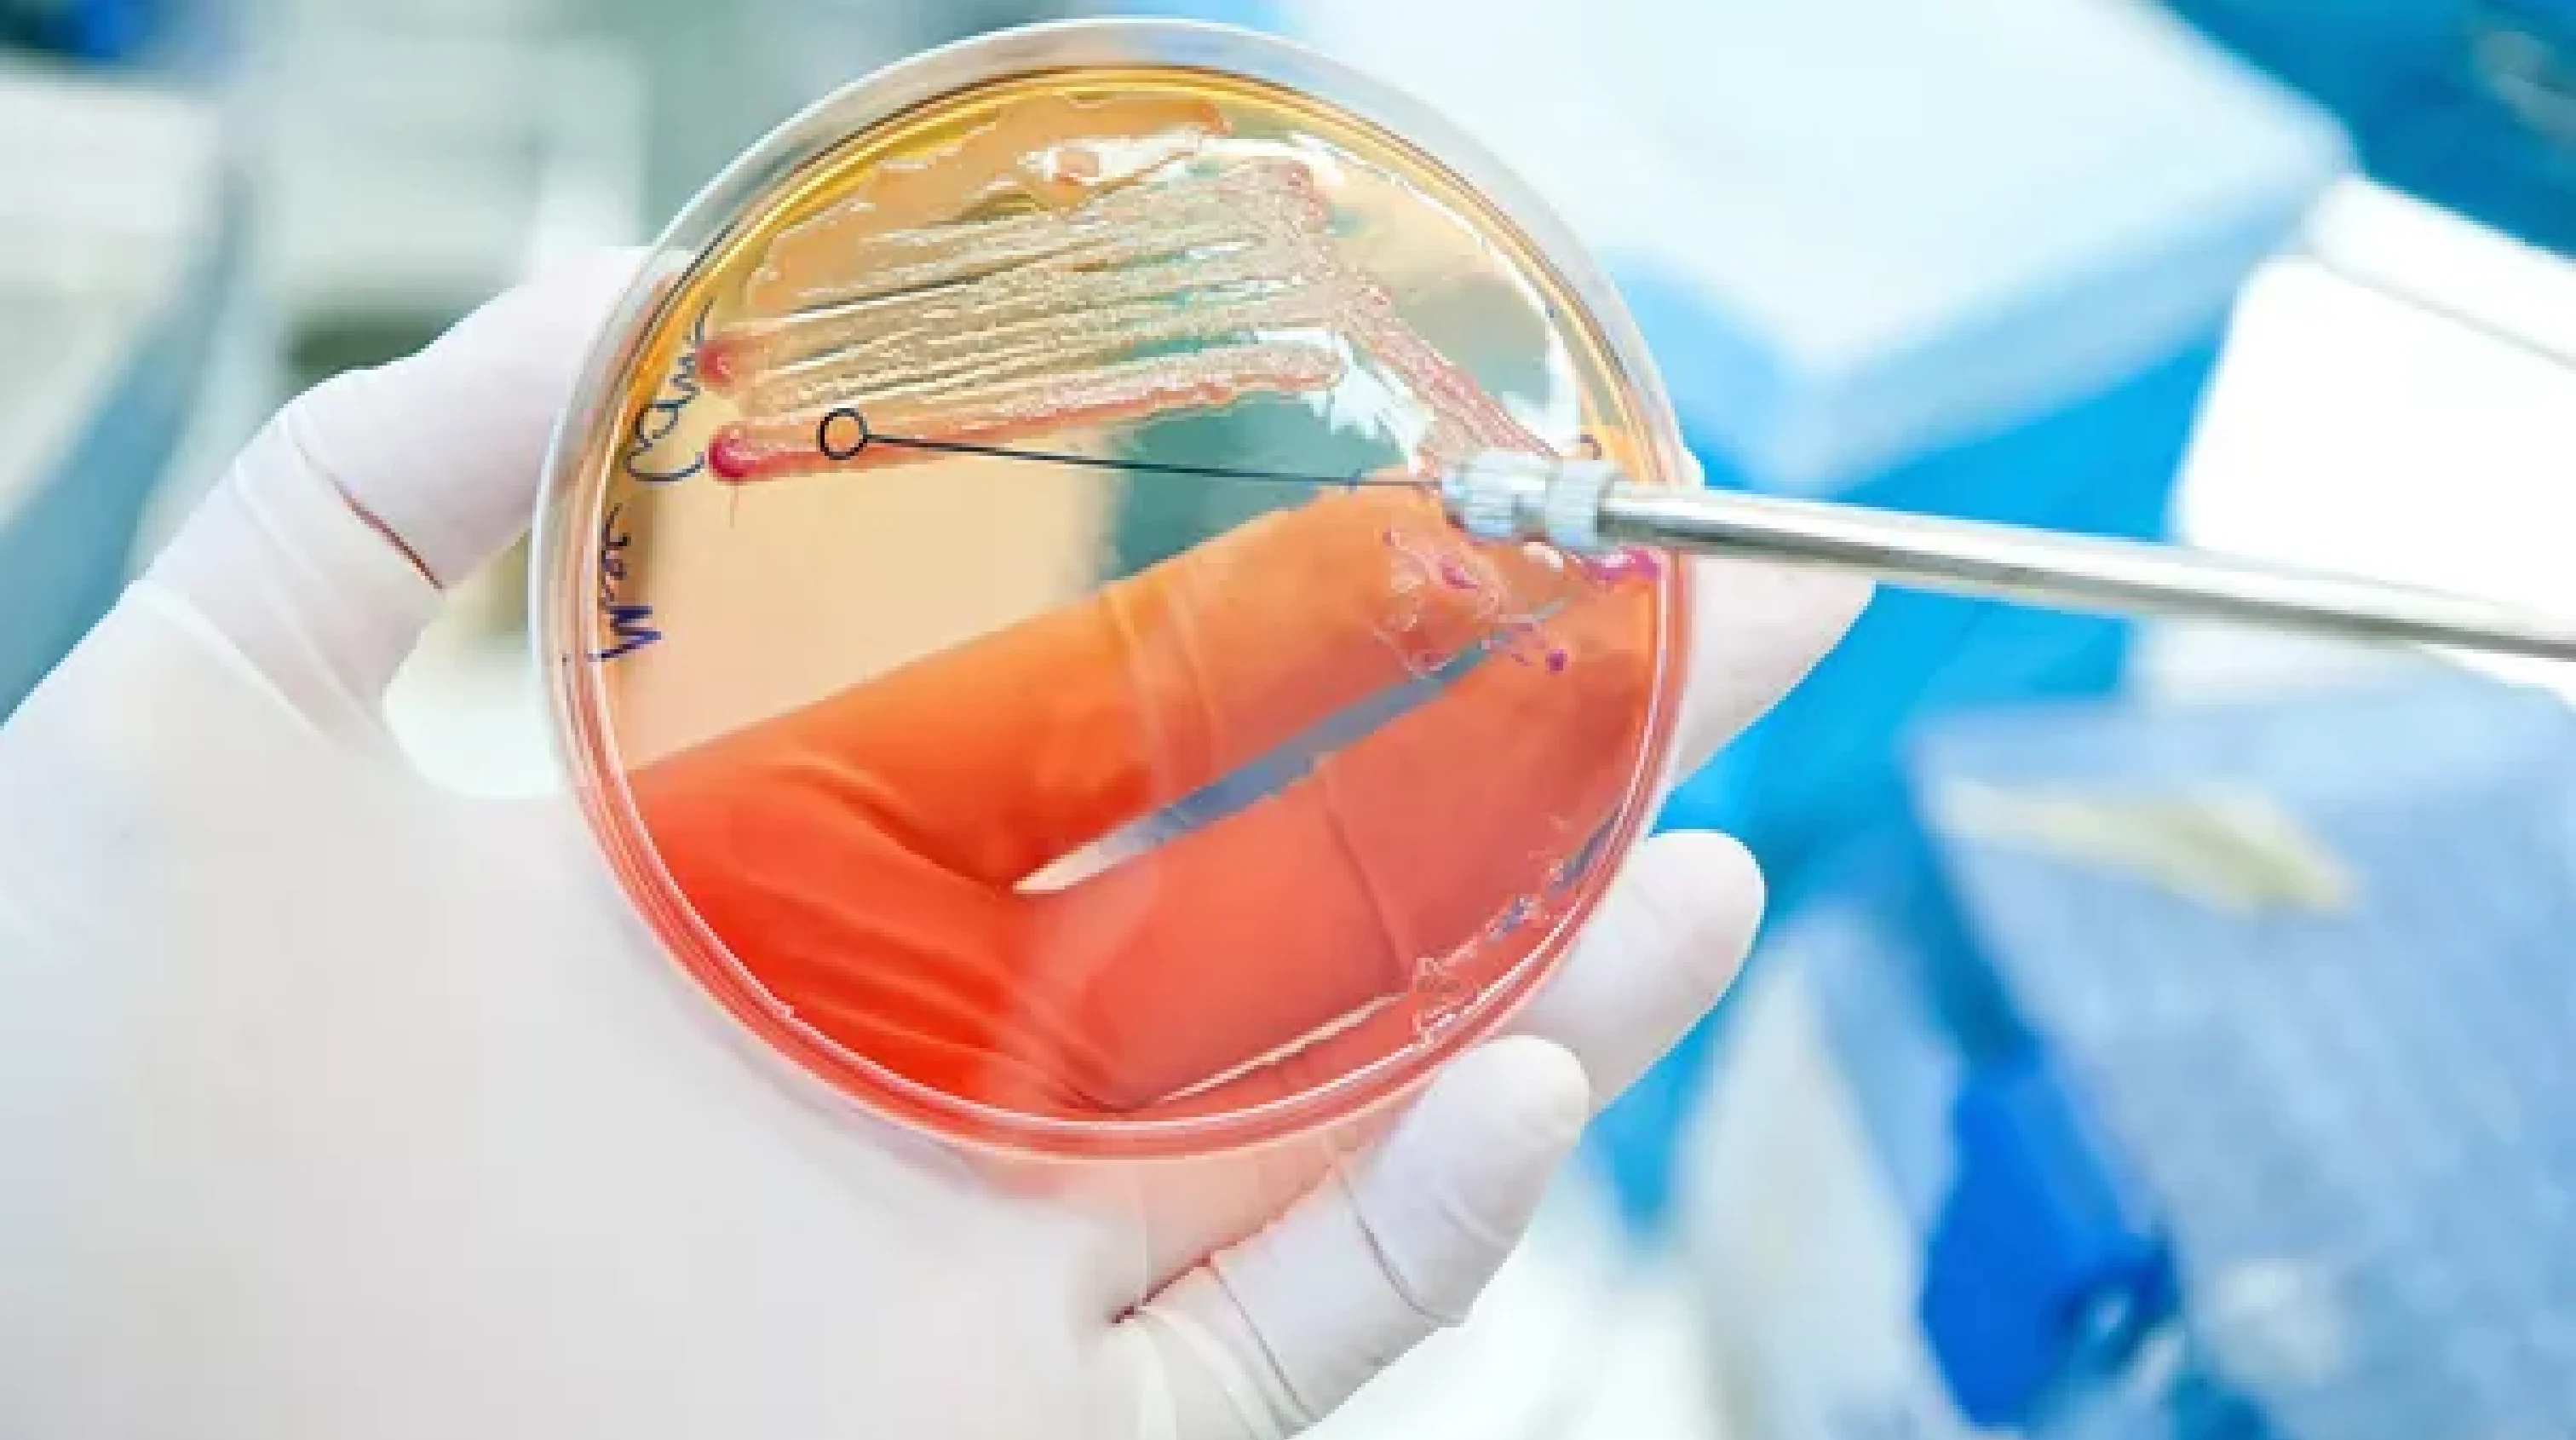
A hand holding culture dish while inoculating dish with loop in the other hand.

Daily Rounds

Middle Ear Inflammatory Polyp Removal in Cats
Removal of aural polyps in cats doesn’t eliminate the risk for recurrence. Researchers asked how feline middle ear anatomy impacts treatment efficacy when a ventral bulla osteotomy is used for removal.
ArticleVideo
Today's Highlights
Author Spotlight

"Canine Cesarean SectionW. Alex Fox-AlvarezAntibiotics are not necessary after uncomplicated cesarean section.
"
DVM, MS, DACVS-SA

"Lymphoma in Young CatsSandra BechtelFine-needle aspiration and cytology can often successfully diagnose large cell lymphoma.
"
DVM, DACVIM
Daily Challenge
Poll
Quiz
Clinical Image
NEW IN CONTINUING EDUCATION
1 HR CE Credit
Sponsored byAntech Diagnostics
1 HR CE Credit
Sponsored byEthicon
1 HR CE Credit
Sponsored byAntech Diagnostics
1 HR CE Credit
Sponsored byAntech Diagnostics
RECOMMENDED FOR YOU
New in podcasts
Podcast: When the Law & Morality Collide
16m:59sEp. 352
New in Drugs & Therapeutics
33m:50s
Ep. 351
Sponsored byZoetis
New in Clinical Skills
Sponsored byHill's Pet Nutrition
New in Client Relationships
New in Practice Life
Sponsored byMWI Animal Health
FROM OUR PARTNERS
Sponsored byMWI Animal Health
Sponsored byNutramax Laboratories
Get more clinical guidance with Standards of Care™
From the team that brings you Clinician’s Brief, extend your knowledge with expert-written, peer-reviewed diagnostic and treatment guidance as well as pet owner education and all the reliable drug information you love in Plumb’s.